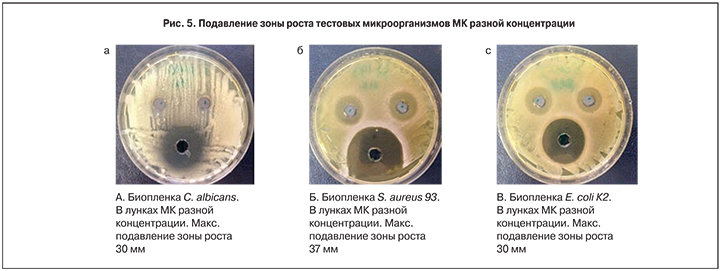

О значении кислой реакции влагалища для защиты от внешних патогенных микроорганизмов и развития тяжелых инфекций матки известно с конца ХIХ века. Еще в 1888 г. К.Ф. Славянский указывал, что «влагалищный секрет» имеет кислую реакцию [1], а в 1893 г. известный российский акушер-гинеколог В.В. Строганов писал: «…кислая реакция благоприятствует развитию нормальной флоры в вагине…» [2]. А. Додерлейн полагал, что физические, химические, половые раздражения, обусловливающие усиленную транссудацию, уменьшают нормальную кислую реакцию влагалища и способствуют таким образом образованию патологического состояния [3]. Многие авторы того периода считали, что патогенные микроорганизмы, попавшие во влагалище, погибают в нем через несколько дней (самоочищение влагалища). Это бактерицидное свойство А. Додерлейн приписывал молочной кислоте, продуцируемой бактериями, нормально находящимися в вагине. Исходя из приведенных наблюдений, что кислая реакция благоприятствует развитию нормальной флоры во влагалище, он применил молочную кислоту в виде спринцеваний 1% раствором при лечении беременных с патологическими выделениями. Результат оказался лучшим, чем при всех других методах лечения. Эта работа А. Додерляйна чрезвычайно интересна и поучительна.
Уже в наши дни доказана важная роль молочной кислоты (МК) в обеспечении защиты влагалища от проникновения патогенных микроорганизмов путем прямого противомикробного действия и опосредованно через иммунокоррегирующее влияние на компетентные клеточные и тканевые структуры влагалищного эпителия [4]. Также недавними исследованиями была продемонстрирована высокая клиническая эффективность различных схем применения молочной кислоты как в режимах монотерапии, так и при его комбинированном использовании с гексиконом или метронидазолом [5, 6] в сравнении с традиционным 2-этапным методом метронидазол плюс ацилакт.
В то же время остаются малоизученными некоторые механизмы антибактериальной активности МК. Вот почему в качестве цели настоящего исследования мы определили изучение in vitro активности 100 мг молочной кислоты, являющейся активным веществом в составе препарата фемилекс (АО Нижфарм).
Материал и методы исследования
В течение 2016 г. все лабораторные исследования проводились на кафедре физиологии медицинского факультета СПбГМУ. Объектами исследования были: препарат фемилекс (АО Нижфарм), суппозитории вагинальные 100 мг. В качестве бактерий антагонистов использовали 2 музейных штамма лактобактерий: Lactobacillus plantarum 8RA-3; Lactobacillus rhamnosus GG АТСС 53103. 2. В качестве готовых пробиотиков, рекомендованных для восстановления микробиоты влагалища, использовали: экофемин флораваг (микробная ассоциация 3 штаммов лактобактерий: L. crispatus, L. brevis и L. acidophilus) в капсулах (Фарма-Винчи, Бельгия); лактожиналь (содержит L. casei rhamnosus Doderleini, производство Лабораратория Лиоцентр САС, Франция). В качестве тестовых культур использовали: Escherichia coli штамм К2 с геном биопленкообразования hly А, В, С; Staphylococcus aureus штамм 93 с геном биопленкообразования ica, и C. albicans.

В данном исследовании при определении минимальной ингибирующей концентрации (МИК) молочной кислоты использовали метод предельных разведений и метод нанесения капель. Также были использованы посев на среду с препаратом; метод O´Toole для изучения биопленкообразования; определение интенсивности биопленкообразования на поверхности полимерных пластиков; микроскопический метод; определение количества микроорганизмов в составе биопленок по Коху; метод двухслойного агара для определения антагонистической активности лактобактерий в присутствии МК по отношению к тестовым культурам; электронная микроскопия, включая трансмиссионную и сканирующую электронную микроскопию с применением позитивного окрашивания и ультратонких срезов.
Результаты исследования
Для изучения МИК МК был приготовлен ряд десятикратных ее разведений в жидкой питательной среде от 10 до 1000 раз. Результаты МИК МК оценивали визуально и при помощи высевов на плотную питательную среду. Полученные данные свидетельствуют о том, что все исследованные лактобактерии проявляют повышенную устойчивость к действию высоких значений рН. Однако производственные штаммы L. plantarum 8RA-3 и L. rhamnosus GG более устойчивы (рост при разведении более чем в 10 раз) по сравнению с культурами из препаратов экофемин и лактожиналь (рост при разведении более чем в 20 раз). Что касается условно-патогенных микроорганизмов (УПМ), то C. albicans оказались наиболее устойчивыми к молочной кислоте и обнаруживали рост при разведениях более чем в 80 раз, тогда как рост бактериальных культур регистрировали только при снижении концентрации кислоты до разведения более чем в 500 раз (S. aureus 93) и более чем в 700 раз (E. coli К2).
При определении по методу O´Toole способности лактобактерий к биопленкоообразованию в норме и в присутствии МК установлено, что микроорганизмы, входящие в состав препаратов экофемин и лактожиналь, проявляют очень слабую способность к образованию биопленок. Эти показатели считают недостаточными для конкурентной адгезии лактобактерий в условиях in vivo. Интенсивность образования биопленок у лактобактерий L. crispatus, L. Brevis, L. acidophilus и L. casei rhamnosus Doderleini в среднем в 3,8 раза ниже, чем у музейных штаммов. При этом МК при разведении в 100 раз стимулировала биопленкообразование лактобактерий, входящих в состав указанных выше препаратов для лечения (таблица).

Влияние молочной кислоты на формирование микробных биопленок
Результаты исследований показали, что биопленки бактериальных культур E. coli К2, S. aureus 93, и грибов C. albicans проявляли чувствительность к МК. В контроле культура S. aureus 93 образовывала сплошной рост в виде биопленки из клеток, погруженных в хорошо сформированный матрикс, КОЕ 3,5×109 клеток/см2 (рис. 1а). В случае биопленки из клеток S. aureus 93 в присутствии МК наблюдали полное подавление биопленкообразования (рис. 1б). В образце обнаружены единичные микроколонии, контуры клеток смазаны, матрикс не сформирован, показатель КОЕ снизился на 6 порядков 1,3×103 клеток/см2.
В контрольном образце E. coli К2 наблюдали хорошо сформированную биопленку, с редкими участками, со сниженной концентрацией клеток, КОЕ 6,7×108 клеток/см2 (рис. 2а). В опытном образце под действием МК рост E. coli К2 подавлен и даже микроколоний обнаружено не было, показатель КОЕ снижался на 6 порядков и составлял 2,0×102 клеток/см2 (рис. 2б).
В контрольном препарате C. albicans обнаружена биопленка. Хорошо различимы дрожжеподобные клетки, заключенные в матрикс, КОЕ 8,6×107 клеток/см2 (рис. 3). В присутствии МК отмечена попытка клеток грибов сформировать ростовые трубки и нити псевдомицелия. Однако это не позволило клеткам выжить, и они лизировались на стадии образования микроколоний, при этом показатель КОЕ снижался на 4 порядка и составлял 3,2×103 клеток/см2 (рис. 3б).
Таким образом, показано крайне негативное влияние МК на формирование биопленок и рост условно-патогенных бактерий и грибов.

Влияние лактобактерий на формирование микробных биопленок
При совместном культивировании УПМ, C. albicans и лактобактерий выявлено антагонистическое воздействие лактобактерий на другие микроорганизмы. Лактобактерии подавляли рост стафилококков, кишечной палочки, грибов C. albicans и формирование их биопленок. Так, в присутствии музейных штаммов и производственных штаммов лактобактерий клетки S. aureus 93 не могли формировать полноценные биопленки, и показатель КОЕ во всех вариантах снижался на 2–3 порядка по сравнению с контролем. При совместном культивировании лактобактерий и E. coli К2 также происходило подавление биопленкообразования, проявляющееся в снижении количества клеток на 3–4 порядка по сравнению с контролем. Культивирование C. albicans в присутствии L. plantarum 8RA-3 и L. rhamnosus GG снижало количество грибов на 2–3 порядка, при этом дрожжевые клетки лизировались, а мицелиальные формы грибов не обнаруживались. Лактобактерии препарата экофемин также снижали количество КОЕ C. albicans на 2 порядка по сравнению с контролем. Лактобактерии же препарата лактожиналь, наоборот, стимулировали образование ростовых трубок и нитей псевдомицелия клетками C. albicans и не мешали клеткам грибов увеличивать показатель КОЕ до контрольного уровня – 3,9×107 клеток/см2.
Влияние молочной кислоты и лактобактерий на формирование микробных биопленок
Формирование биопленок тестовыми микроорганизмами в присутствии лактобактерий и молочной кислоты характеризовалось уменьшением роста культуры S. aureus 93, показатель КОЕ оставался ниже контрольного на 6 порядков, при этом образования биопленок не происходило. Характер роста и формирования биопленок клетками E. coli К2 также мало отличался от такового при культивировании в присутствии МК. Однако обращает на себя внимание прирост количества лактобактерий в образцах с L. rhamnosus GG.
Особенности роста и формирования биопленок C. albicans сходен с таковым при культивировании грибов в присутствии МК. Во всех образцах присутствовали мицелиальные и дрожжевые формы, однако при культивировании C. albicans в среде с лактожиналем и фемилексом обнаружено большое количество лизированных клеток, в отличие от образца без фемилекса. А при росте C. albicans в среде с экофемином обнаружено большое количество мицелиальных нитей, в то время как при культивировании в присутствии фемилекса мицелиальные формы клеток встречались крайне редко. Эти результаты свидетельствуют о том, что при одновременном применении с МК наблюдается усиление эффекта пробиотиков.
Показатель КОЕ тестовых микроорганизмов при совместном культивировании с лактобактериями в присутствии МК и без нее
Показатели количества клеток тестовых микроорганизмов при совместном культивировании с лактобактериями в присутствии МК и без нее представлены на рис. 4.
Полученные данные свидетельствуют, что рост культур S. aureus 93, E. coli К2, C. albicans и развитие их биопленок существенно подавляются за счет комбинации пробиотических штаммов лактобактерий с молочной кислотой, что свидетельствует об их синергитическом действии. Действие молочной кислоты в сочетании с пробиотиками на все тестируемые культуры выражалось в подавлении роста УПМ в 2,5–4 раза относительно контрольных показателей, что в среднем в 2 раза эффективнее действия только живых культур лактобактерий без добавления МК.
Изучение культивирования тестовых микроорганизмов в присутствии МК показало, что рост C. albicans, S. aureus 93 и E. coli К2 ингибируются при ее исходной концентрации. МК в концентрации 100 мг (препарат фемилекс) образует заметную зону подавления роста тестовых культур (рис. 5).
При анализе действия МК на лактобактерии (метод лунок) выявлены зоны избыточного роста молочнокислых бактерий вокруг лунок с МК (рис. 6), чего не наблюдалось в контрольном образце с физиологическим раствором. Эти результаты свидетельствуют, что МК стимулирует рост и образование биопленок L. rhamnosus GG.
Применение электронной микроскопии позволило выявить изменения морфологических свойств клеток различных видов микроорганизмов под действием молочной кислоты, что свидетельствует о деструктивном ее воздействии как на грамотрицательные бактериальные клетки, так и на C. albicans. Клетки грамположительных тестируемых штаммов под воздействием МК переходили в состояние физиологического покоя, не проявляя биологической активности. Эти результаты подтверждают данные литературы, которые свидетельствуют, что МК обладает специфическим антисептическим механизмом действия (разрушение бактериальной мембраны), который отсутствует у других кислот (аскорбиновой и уксусной) [4].
Важно отметить, что электронно-микроскопический анализ клеток L. plantarum 8RA-3, выращенных в виде биопленок в контрольных условиях и в присутствии МК, не выявил отличий в морфологии клеток лактобактерий и в ультратонком строении их биопленок, что является убедительным доказательством устойчивости лактобактерий к антимикробному действию МК.
Обсуждение
Одним из наиболее важных защитных механизмов предотвращения развития инфекций женских половых путей является кислотность влагалища, которая в норме обеспечивает за счет образования молочной кислоты поддержание рН в интервале 3,5–4,5.
Теоретическое обоснование окисления влагалища при различных инфекционных процессах нашло свое применение в ряде клинических исследований [7–9]. При этом МК отводится главенствующая роль как наиболее физиологического компонента в качестве самостоятельного средства или в комплексном лечении БВ. Очень интересным оказалось то обстоятельство, что при использовании МК наблюдалась более выраженная активация роста числа лактобактерий, чем в группе с пробиотиком. Это факт может быть объяснен тем, что лактобактерии, содержащиеся в пробиотиках, не восполняют их дефицит во влагалище, так как по микробиому являются генетически чужеродными и быстро погибают. Механизм восстановления собственных лактобактерий при использовании пробиотиков еще малоизучен. Напротив же, МК создает максимально физиологические условия влагалищной среды и способствует росту собственных лактобактерий до нормальных значений очень быстро.
В настоящем исследовании получены новые данные о сочетанном действии лактобактерий и МК, проявляющемся в выраженном бактерицидном действии на УПМ, грибы вида Candida albicans и их пленкообразование, которое наблюдается именно при добавлении МК к лактобактериям. Эти результаты объясняют механизмы антибактериальной активности на клеточном уровне и клиническую эффективность, описанную в более ранних публикациях. Нами установлено, что МК потенцирует не только антибактериальные препараты (хлогексидин, метронидазол), но и пробиотики, выступая очень важным и, по сути, универсальным средством в лечении инфекций влагалища. Таким образом, проведенное изучение активности МК на образование биопленок лактобактерий и УПМ, а также на грибы рода Candida имеет не только фундаментальное значение, но ориентировано на конкретные прикладные цели. А именно, объясняет механизм действия МК в качестве лекарственного средства при лечении бактериальных и, возможно, грибковых вагинальных инфекций.
Настоящая работа является первым фундаментальным исследованием МК в качестве основного фактора в поддержании локального биологического гомеостаза влагалища.
Выводы
- МК обладает противомикробным действием, подавляет развитие культур УПМ: E.coli К2 – в 4 раза, S. aureus 93 в 2,6 раза и грибы C. albicans в 2,4 раза по сравнению с контролем, а также препятствует формированию ими биопленок.
- МК изменяет морфологические свойства в клетках УПМ и грибов (деструкция клеток и образование покоящихся форм в популяциях исследуемых культур), их функциональное состояние.
- МК не ингибирует рост микроорганизмов рода Lactobacillus spp. и стимулирует рост культуры лактобактерий L. rhamnosus GG.
- МК при разведении в 100 раз стимулирует образование биопленок лактобактерий, входящих в состав препаратов лактожиналь и экофемин.
- Обнаружено сочетанное действие МК и музейных штаммов лактобактерий (L. rhamnosus GG, L. plantarum 8RA-3), в результате которого ингибирующий эффект препарата на тестовые культуры УПМ и грибов возрастал в 2 раза, а также усиление противомикробного действия пробиотиков при их совместном применении с МК.
- МК проявляет в среднем в 2 раза большую антимикробную активность по сравнению с пробиотиками (лактожиналь и экофемин) в отношении условно-патогенных бактерий и грибов.
- Полученные результаты настоящего исследования позволяют сделать прогноз о высокой клинической эффективности при минимальном количестве нежелательных явлений применения молочной кислоты (фемилекса) в сочетании с пробиотиками для лечения и профилактики инфекционных заболеваний влагалища, включая, возможно, и вульвовагинальный кандидоз.



